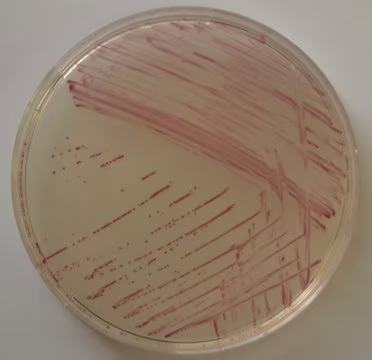
Chromocult® Enterococci-Agar, 1 X 500 g (1009500500)

Bulk Discount Available!

Chromocult® Enterococci-Agar, 1 X 500 g (1009500500)
MilliporeSigma® (Sigma-Aldrich)
$901.94
Earn points on this purchase